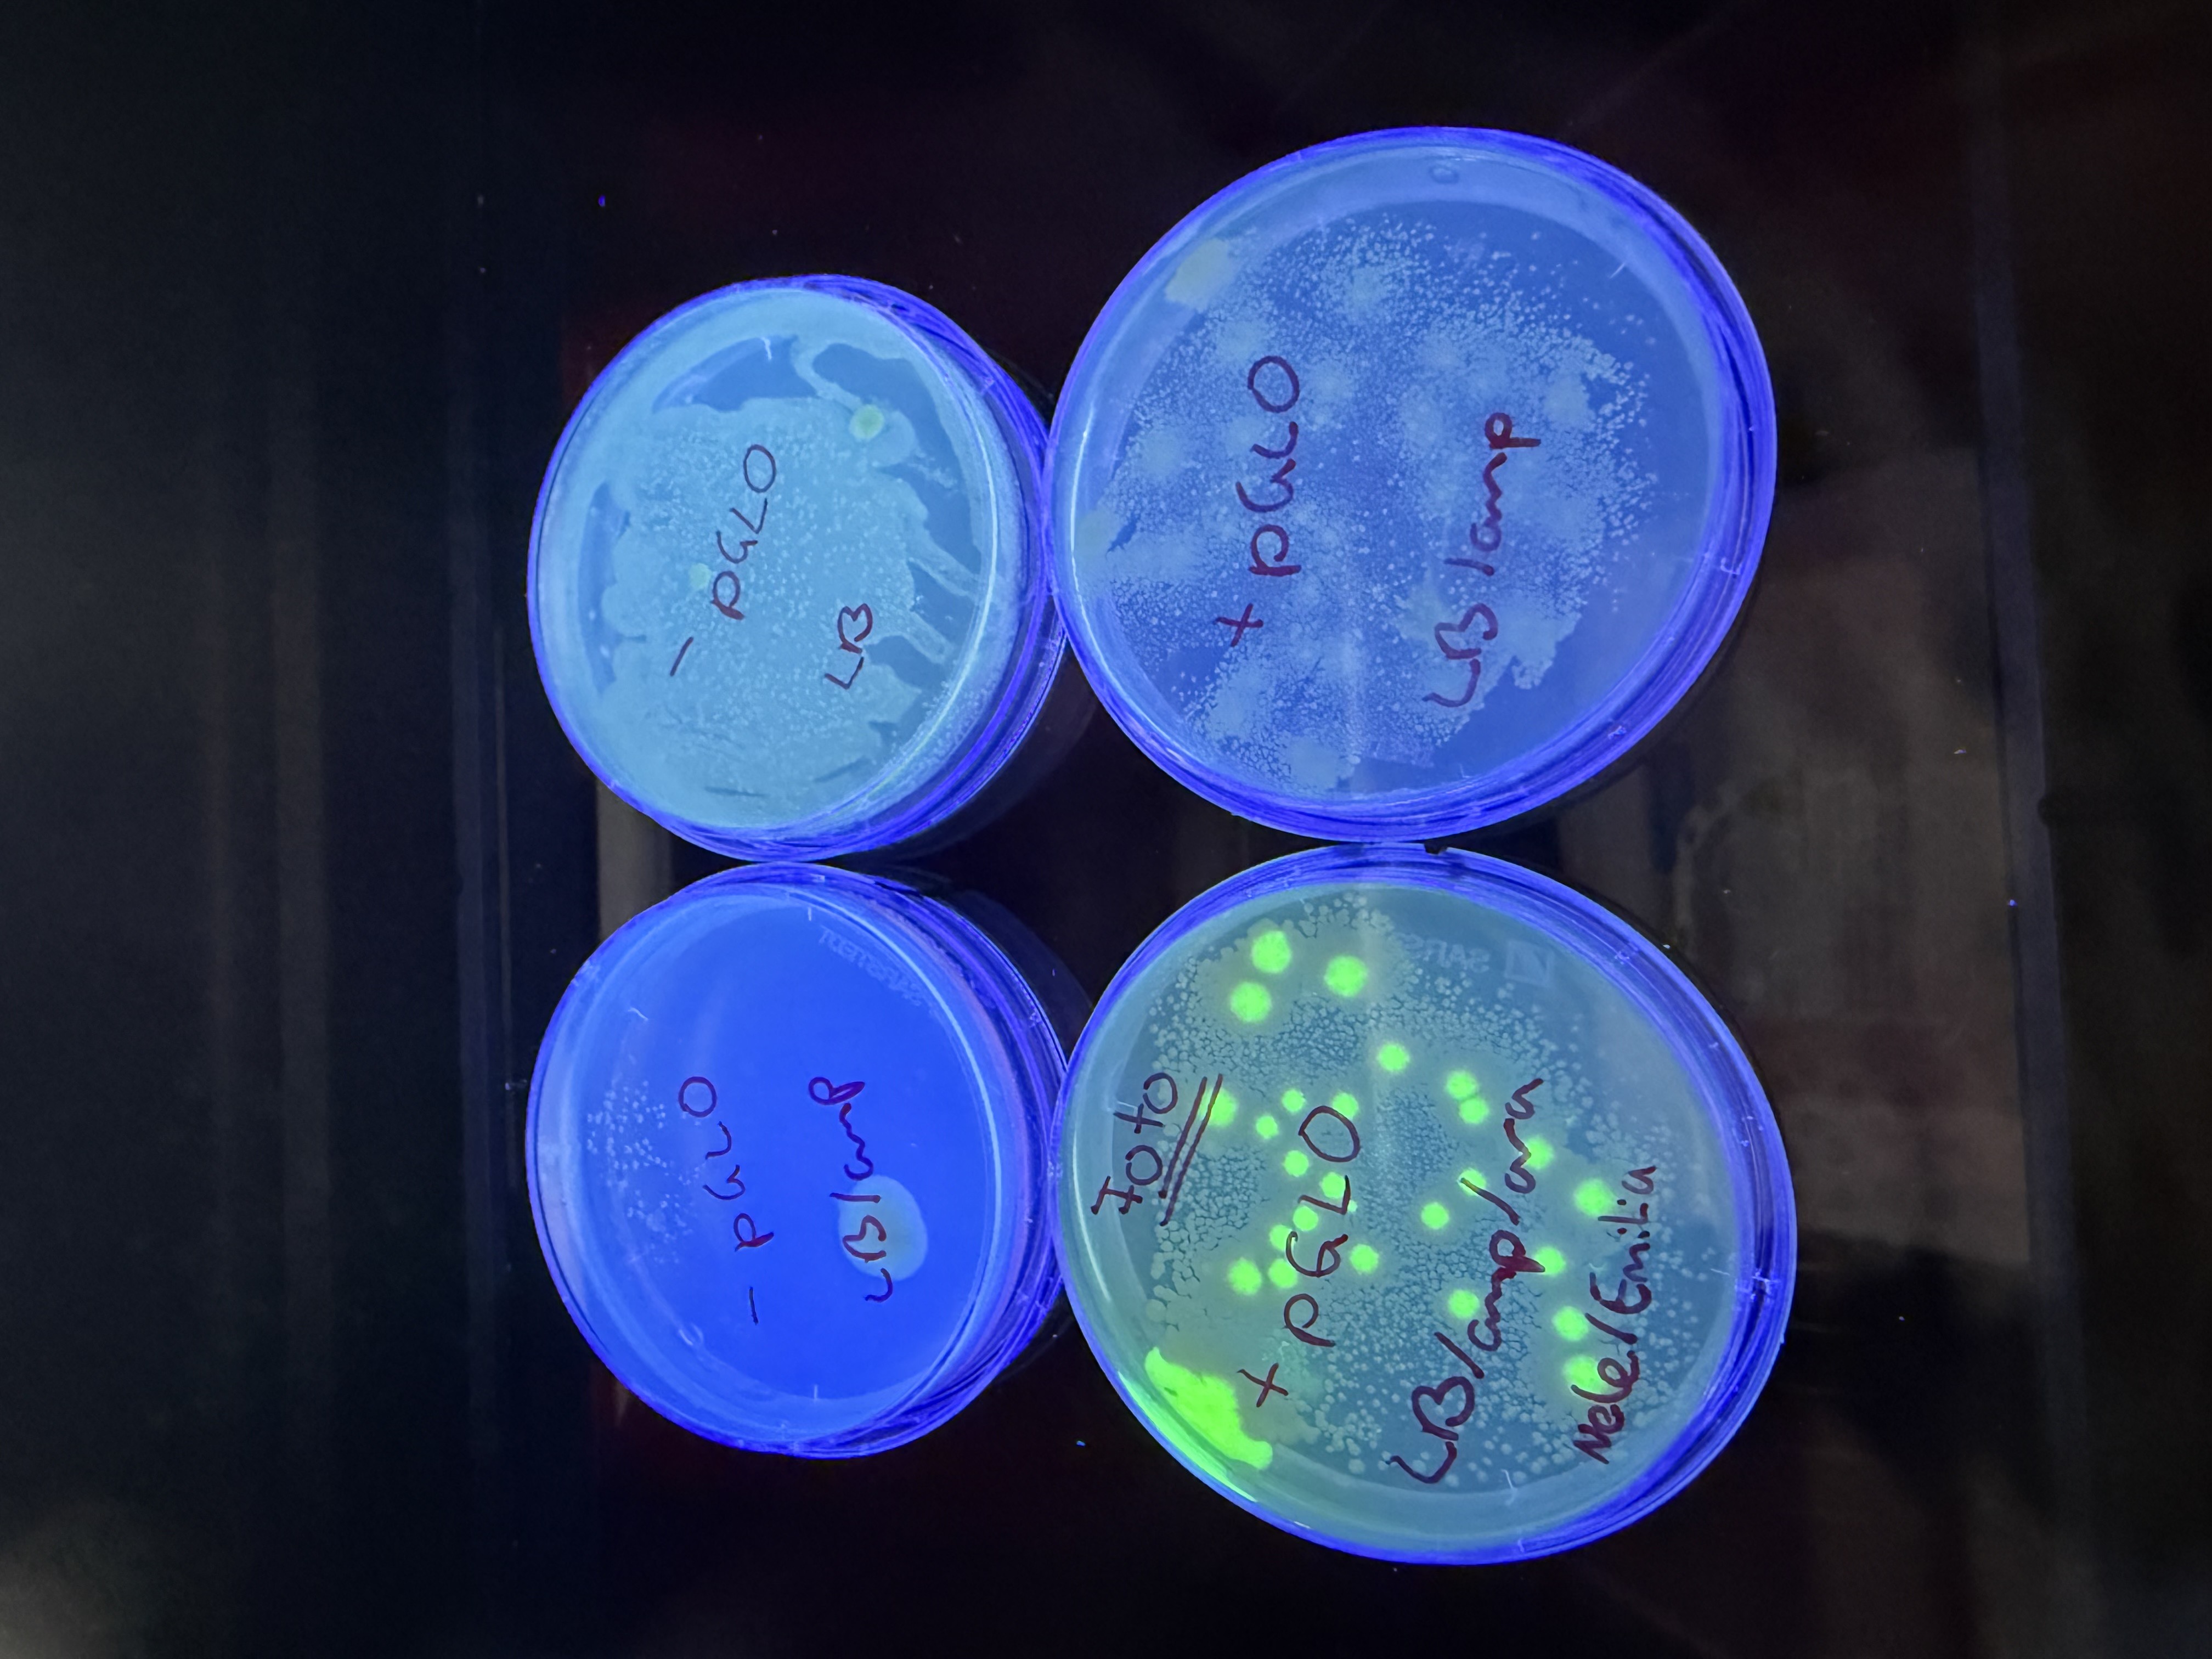

Der J2-Leistungskurs in Biologie unternahm am Mittwoch, dem 15. Januar 2025 und am Dienstag, dem 21.01.2025 eine Exkursion zum Forschungsgewächshaus Phytotechnikum an der Universität Hohenheim.
Wir starteten mit einem 35-minütigem Theoriemodul. Am Mittwoch durften wir Schüler*innen danach unter der Leitung von Corina Mayer, selbstständig in Zweiergruppen einen GVO – Transformationsversuch durchführen. Wir haben unter anderem gelernt, wie man richtig mit Micropipetten pipettiert und eine Gelelektrophorese durchführt.
In der folgenden Woche konnten wir unsere Praxiskenntnisse bei einer DNA-Analyse anwenden. Durch die praktische Arbeit in einem professionellen Labor konnten wir viele Erfahrungen sammeln und die theoretischen Zusammenhänge, die wir im Unterricht besprochen haben, besser nachvollziehen und verknüpfen. Die Führung über das Campusgelände und das Essen, das wir in der Mensa genießen durften, haben uns das Studentenleben nähergebracht. Insgesamt sind wir sehr begeistert vom Schülerpraktikum und der Vielseitigkeit der Angebote an der Universität Hohenheim und bedanken uns für die zwei lehrreichen Tage im Phytotechnikum. [von Maja, Julia und Stella]